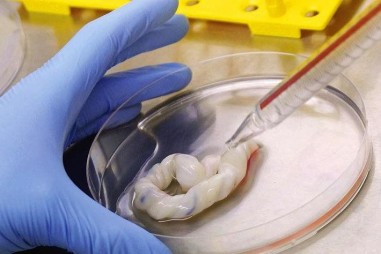
Tế bào gốc điều trị bệnh phổi tắc nghẽn mạn tính
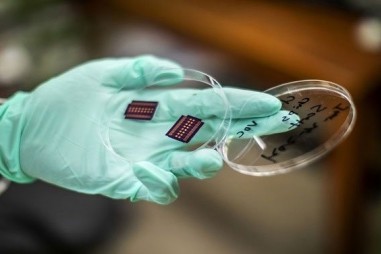
"Mũi điện tử" phát hiện tế bào ung thư trong mẫu máu

Thuốc kháng sinh có thể giúp điều trị u ác tính
TNNN - Thuốc kháng sinh khai phá một lỗ hổng phát sinh trong các tế bào khối u khi chúng cố gắng sống sót sau liệu pháp điều trị ung thư.

TNNN - Thuốc kháng sinh khai phá một lỗ hổng phát sinh trong các tế bào khối u khi chúng cố gắng sống sót sau liệu pháp điều trị ung thư.

TNNN - Các nhà nghiên cứu ở Melbourne đã xác định được một cách để cải thiện phản ứng miễn dịch khi đối mặt với tình trạng nhiễm virus nghiêm trọng.

TNNN - Việc ứng dụng thành công tế bào gốc trong điều trị đột quỵ nhồi máu não của nhóm nghiên cứu ở Bệnh viện Trung ương Quân đội 108 đã mở ra hy...

TNNN - Các nhà khoa học đang ngày càng hiểu rõ cơ chế COVID-19 gây hại cho não. Các nghiên cứu mới cho thấy virus SARS-CoV-2 có thể tấn công não theo...

TNNN - Kết quả thử nghiệm gợi ý rằng việc giảm liều tiêm có thể giúp giải quyết tình trạng thiếu vaccine COVID-19 trầm trọng trên thế giới.

TNNN - Sàng lọc ảo 6.218 loại thuốc và xét nghiệm dựa trên tế bào xác định các ứng cử viên thuốc điều trị tốt nhất

TNNN - Một loạt nghiên cứu cho thấy việc trộn vaccine sẽ tạo ra phản ứng miễn dịch mạnh mẽ, nhưng cũng gây ra những tác dụng phụ hiếm gặp.

TNNN - Một liều psilocybin duy nhất cho chuột sẽ thúc đẩy sự gia tăng kết nối ngay lập tức và lâu dài giữa các tế bào thần kinh.

TNNN - Các nghiên cứu gần đây cho thấy, liệu pháp tế bào gốc có thể cải thiện các triệu chứng của các bệnh tự miễn dịch (AD) thông qua ba cơ chế:...

TNNN - Biết được cách thức và lý do protein phát triển có thể giúp các nhà khoa học hiểu và thiết kế hoạt động của protein,

TNNN - Phát hiện này làm sáng tỏ về cách hệ thống miễn dịch được cảnh báo để tấn công những virus xâm nhập.

TNNN - Một đột biến ở vị trí số 484 trên protein hình gai cho phép nCoV xâm nhập tế bào trong cơ thể người mà không cần liên kết với thụ thể ACE2 như...

TNNN - Các nhà khoa học từ lâu đã thắc mắc về tuổi thọ đáng kinh ngạc lên đến 100 năm của loài tôm hùm: chúng không yếu đi theo năm tháng và hiếm khi...
TNNN - Các nhà khoa học thuộc Học viện Quân y vừa thực hiện thành công đề tài nghiên cứu ứng dụng tế bào gốc trung mô đồng loài trong điều trị bệnh...

TNNN - Trong một khám phá thách thức những giáo lý lâu đời trong sinh học, các nhà nghiên cứu chỉ ra rằng tế bào động vật có vú có thể chuyển đổi...

TNNN - Cơ quan quốc tế ISSCR đã nới lỏng lệnh cấm nuôi cấy phôi thai người trong phòng thí nghiệm quá 14 ngày, mở đường cho các nghiên cứu , có thể...

TNNN - Phương pháp đo tế bào dòng chảy cho phép các nhà nghiên cứu mở rộng khả năng của phép đo tế bào để sàng lọc thông lượng cao, đồng thời thu...

TNNN - Tổ chức của hệ gene con người phụ thuộc vào tính chất vật lý của các trạng thái khác nhau của vật chất – như trạng thái lỏng và trạng thái...

TNNN - Chiết xuất liti với độ tinh khiết cao từ nước biển
TNNN - Công cụ này có thể nhận biết sự khác nhau của hợp chất hữu cơ dễ bay hơi phát ra từ tế bào ung thư và tế bào bình thường trong huyết tương.

TNNN – Từ việc tìm ra cách hồi sinh các tế bào miễn dịch mạnh, mở ra cơ hội để thúc đẩy việc áp dụng vào liệu pháp điều trị ung thư ở người.

TNNN - Một số quần thể tế bào thần kinh xử lý cảm giác và ký ức cùng một lúc. Nghiên cứu mới cho thấy cách bộ não xoay chiều các biểu diễn thần kinh,...